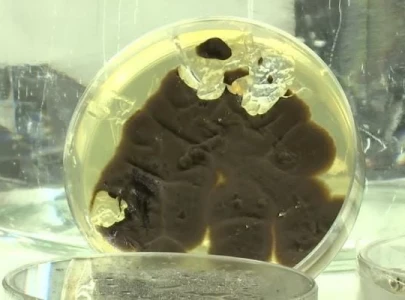
fungi that consume plastic may be key to tackling ocean pollution

Technology
More News
-
'Time hacking' GPS spoofers target commercial airlines, researchers say
There has been a 400% surge in GPS spoofing, incidents affecting commercial airliners in recent months
-
ISS astronaut captures 'Wall of haze' above Pakistan
A 2023 NASA photo captures the Sulaiman Mountains, revealing thick haze and clouds trapped behind the towering peaks
-
How is AI shaping our lives and what does the future hold?
AI-driven assistants, smart homes, healthcare apps are boosting efficiency, personalization, convenience in daily life
-
Oxford scientists develop material to transform everyday objects into solar panels
The ultra-thin and flexible film is made by stacking layers of light-absorbing perovskite and only a micron thick
-
Want to improve heart health? A baked potato might be the answer
Participants who consumed potatoes showed a modest decrease in fasting blood glucose levels, and good heart rate
-
Western trophy hunts drive Africa’s last 23,000 captive lions toward extinction
The cost of hunting parties ranges from $4,000 to $60,000 in 2024, depending on the type of hunt and tour
-
China unveils new unmanned rescue system for tunnel emergencies
The system has undergone successful trials related to autonomous navigation in tunnels and rescue efforts
-
TikTok unveils ‘Spotlight’ to boost film and TV promotion on platform
The option provides a more comprehensive way for studios to tap into the app’s hype and engage fans.
-
Fungi that consume plastic may be key to tackling ocean pollution
Some 390 million tonnes of plastic were produced worldwide in 2021 and majority of ends in the oceans
-
Breakup of Chinese rocket threatens over 1,000 satellites, other space objects
US space-tracking firm LeoLabs said it was likely the number of debris pieces exceeds 900
-
World's largest 3D-printed neighborhood nears completion in Texas
The 3D-printed homes at Wolf Ranch, called the "Genesis Collection" by developers, starting from $450,000
-
Researchers extract deepest-ever rock sample from Earth's mantle
Scientists extract rock from Earth's mantle - penetrating 4,160 feet (1,268 meters) below the Atlantic seabed
-
Warming Mars: scientists propose using reflective 'glitter' to trap heat
Scientists are proposing a new approach to warm up Mars by pumping engineered particles of Iron or aluminum
-
Israeli army leverages tech giants for data storage in Gaza conflict
The Israeli army has been using Amazon’s cloud service and AI tools from Microsoft and Google
-
How Intel missed the AI wave by turning down OpenAI
For the first time in 30 years, the tech company is worth less than $100 billion
-
Pakistani students triumph at Nuclear Science Olympiad, bag 2 silver and 2 bronze medals
The Olympiad held in Clark, Philippines from August 01-06, 2024, was sponsored by the IAEA
-
Samsung's 8-layer HBM3E chips pass Nvidia's testing, sources confirm
Samsung and Nvidia have yet to sign a supply deal for the approved eight-layer HBM3E chips
-
Greenland's fossils expose heightened sea-level risks due to climate change
Ancient fossils under Greenland’s ice reveal past complete melting, raising sea-level rise concerns if it reoccurs
-
Quantum computing prepares for a revolutionary leap following AI's breakthrough
The Riverlane company produces the world's first dedicated quantum decoder chip, which detects and corrects the errors
-
Musk’s X sues advertisers for boycotting platform
X files lawsuit in federal court in Texas against World Federation of Advertisers, Unilever and Orsted
-
Discovery of tiny arm bone sheds light on Indonesia's extinct 'Hobbit' people
Based on the bone's size, the researchers concluded the individual stood about 3 feet 3 inches tall
-
TikToK founder company joins OpenAI's Sora rivals with AI video app launch
Jimeng AI, developed by ByteDance-owned Faceu Technology, is now available on the Apple App Store for Chinese users
-
US judge rules Google has an illegal search monopoly
Ruling paves way for second trial to determine potential fixes, including a breakup of Google parent Alphabet
-
OpenAI co-founder quits, joins rival company Anthropic
OpenAI faces staffing shifts as co-founder Schulman moves to competitor Anthropic
-
US judge rules Google is monopoly in key anti-trust case
The landmark decision against a "big tech" giant could alter how the sector operates in future
-
China successfully tests 1,000 km per hour UHS Maglev train
The test was conducted by a superconducting maglev vehicle in a 2-km-long pipeline with a low-vacuum environment
-
China begins satellite constellation to compete with Starlink: report
The launch is part of SSST's "Thousand Sails Constellation" plan, also known as the "G60 Starlink Plan"
-
'Lunar zoo': Scientists plan to save endangered species by taking them to the Moon
Lunar biorepository would target the most at-risk species on Earth today by cryopreserving them
-
Inbred, gibberish or just MAD? Warnings rise about AI models
Research studies have shown how AI programs like ChatGPT continuously fed their own data which is a major drawback
-
China reports Five human cases of skin anthrax
Cases found at a beef cattle farm in Yanggu county in eastern Shandong province
-
Delay to Nvidia's new AI chip could affect Microsoft, Google, Meta, the Information says
Meta ,Google and Microsoft, have already ordered tens of billions of dollars' worth of chips
-
How to use WhatsApp without an internet connection
Stay connected with WhatsApp's new proxy feature, even when your internet is down
-
Weathering the storm, Pakistani startups sail on
Navigating a decline in seed funding, the country’s startups remain optimistic about the future
-
Threads accelerates user growth, hits 200 million milestone
The user growth rate tripled over the last month which shows significant addition in the users
-
Scientists create biodegradable material to improve wound healing, skin regeneration
The biocomposite material is made from silk fibroin, sodium alginate and other natural polymers
-
Large-scale video generation model developed in China now accessible worldwide.
Vidu is capable of creating 4-second clips in 30 seconds and can generate videos up to 32 seconds long in one go
-
US courts face a new copyright dilemma as music labels file AI lawsuit
The interplay of melody, harmony and rhythm can make it harder to determine which part is infringement of copyright
-
PTA plans measures to block VPNs in Pakistan amid rising usage
Ban on VPN's in Pakistan likely to impact IT businesses dependent on unrestricted internet access.
-
Meteorite impacts identified as driver of moon's tenuous atmosphere
After decades of studying the moon, scientists are still learning about some of its basic processes
-
Scientists achieve breakthrough in mosquito-borne disease control
The device separates male and female mosquitoes for biological control and sold to many countries
-
New AI 'Friend' necklace designed to combat loneliness
The wearable device is a pendant called Emily, an AI friend who always talk with you
-
Egypt’s ‘screaming’ mummy woman may have died in pain and spasms
Scientists performed CT scans that shows the woman was suffering from cadaveric spasm or muscular stiffening
-
Striking US video game actors warn AI threatens jobs
Video game voice actors call strike over failed labor contract negotiations focus on AI related workers protections
-
Meta reports strong global ad sales while managing AI costs
Facebook and Instagram parent says it anticipates third-quarter revenue in range of $38.5 billion to $41 billion
-
Typhoons forming closer to coast due to Climate Change: Study
Research shows "increased formation near coastlines and slower movement over land”, which pose new risks
-
Bot-like accounts on X spreading US political conspiracies: Watchdog
45 accounts analyzed by Global Witness, which collectively generated more than four billion impressions since May
-
NASA image reveals complex evolution of two near-Earth asteroids
An analysis of the craters and surface strength on Didymos indicated it formed about 12.5 million years ago
-
"Avowed": Action RPG set on mysterious island launches this year
"Avowed" offers a mix of first and third-person perspectives, Players can use magic, melee weapons, and firearms
-
Meta agrees to $1.4 billion settlement in Texas facial recognition data lawsuit
Alphabet’s Google separately is fighting a lawsuit by Texas accusing the company of violating biometric law.
-
UK regulators scrutinize Google parent's partnership with AI startup Anthropic
Anthropic's Claude AI models have vied for prominence with OpenAI's GPT series

1723017334-0/BeFunky-collage]___-(4)1723017334-0-405x300.webp)

1722932569-0/BeFunky-collage]_-(43)1722932569-0-405x300.webp)
1721986403-0/BeFunky-collage]-(47)1721986403-0-405x300.webp)

























